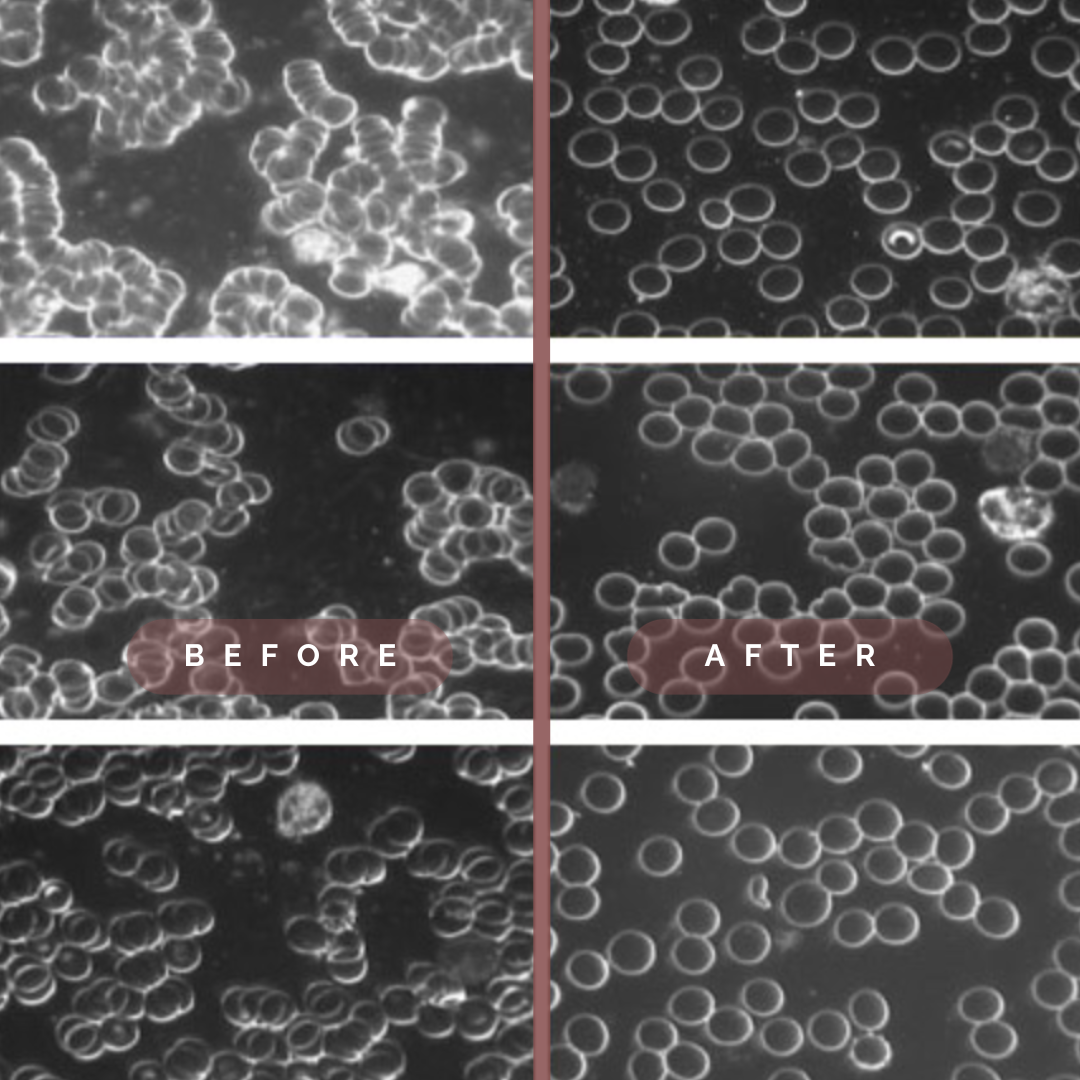

Einstecken & Genießen.
Steigern Sie Ihre Gesundheit mit natürlicher Erdung von Zuhause.
Thermografie-Aufnahmen zeigen den anti-entzündlichen Effekt der Erdung.
















































Echte Ergebnisse, die man sieht und spürt
Entdecke die wissenschaftlich fundierten Vorteile der Erdung durch unsere hochwertige Magnaroot™ Original Erdungsmatte. Reduziere Stress, verbessere deinen Schlaf und förder deine Gesundheit auf der Grundlage zahlreicher Studien und bewährter wissenschaftlicher Erkenntnisse.
-
Lindert Entzündung
Indem sie dem Körper die benötigten negativen Elektronen liefert, um ein Gleichgewicht herzustellen.
-
Fördert Herzgesundheit
Magnaroot™ fördert durch die Aktivierung des Parasympathikus, auch bekannt als 'Ruhenerv', Entspannung und Erholung, was sich positiv auf die Herzgesundheit auswirkt.
-
Neutralisiert EMF
Wirkt als Barriere gegen schädliche elektromagnetische Strahlen. Durch die Erdung werden EMF-Strahlen neutralisiert, die von elektronischen Geräten ausgehen.
Erstaunliche Bilder von Blutproben
Dunkelfeldaufnahmen von Probanden unmittelbar bevor und nachdem sie für 40 Minuten geerdet waren, zeigen überzeugend, dass Erdung in nur kurzer Zeit zu einer verbesserten Blutzellstruktur führt.

Anti-Aging dank Magnaroot™
Fördert nicht nur Ihr Wohlbefinden, sondern auch eine gesunde Haut. Durch die direkte Verbindung mit der Erde werden Antioxidantien aufgenommen, die schädliche freie Radikale neutralisieren können. Dieser Prozess hilft, die Hautalterung zu verlangsamen und ein jugendliches Strahlen zu bewahren.

Störfrequenzen haben keine Chance!
In unserer modernen Umgebung setzen uns zahlreiche elektronische Geräte wie Computer, Handys, TV, WiFi und Bluetooth einer Vielzahl von elektromagnetischen Strahlungen aus. Diese Strahlung erzeugt elektrische Spannungen in unseren Körpern, die wiederum die feinen, elektrischen Kommunikationen stören, die für die reibungslose Funktion unseres Organismus entscheidend sind. Dank Magnaroot™ reduzieren wir diese induzierten elektrischen Spannungen durch einen Ladungsausgleich mit der Erde signifikant.
Häufig gestellte Fragen
Wie funktioniert Magnaroot?
Die Magnaroot™ Original Matte enthält leitfähige Materialien, die den elektrischen Kontakt mit der Erde ermöglichen. Dies fördert den Fluss von Elektronen, unterstützt den Ausgleich von elektrischen Ladungen im Körper und hilft, die Vorteile der Erdung zu erleben und das fast überall wo Sie sich befinden.
Gibt es wissenschaftliche Erkenntnisse über Erdung?
Ja, es gibt wissenschaftliche Forschung, die die Vorteile des der Erdung unterstützt. Studien haben gezeigt, dass der direkte Kontakt mit der Erde den Elektronenfluss im Körper beeinflussen kann, was sich positiv auf Entzündungen, Stressniveaus, Schlafmuster und andere gesundheitsrelevante Faktoren auswirken kann. Weitere Informationen
Welche Vorteile bietet eine Magnaroot™ Original Erdungsmatte?
Dank unserer Doppelt- Carboninfundierten Oberfläche sind unsere Matten für die Ewigkeit gemacht.
Ob bei der Arbeit im Büro, Zuhause beim Entspannen oder beim Schlafen. Mit Magnaroot bleiben sie 98% Ihres Tages geerdet. Unsere Matten können dazu beitragen, Stress zu reduzieren, den Schlaf zu verbessern, die Energie zu steigern, den Fokus zu erhöhen, die Entzündung zu verringern und die allgemeine Gesundheit und das Wohlbefinden zu fördern.
Benötigt die Verwendung Strom?
Nein, unsere Matte selbst benötigt keinen Strom. Der Anschluss in die Steckdose dient dazu, eine Verbindung mit der Erdung herzustellen, nicht um elektrische Energie zu liefern. Die Matte wirkt als leitfähiger Kanal, der es ermöglicht, elektrostatische Ladungen sicher abzuleiten. Das macht Magnaroot™ einfach und sicher in der Anwendung, ohne zusätzliche Energiekosten.
Kann die Matte auf Reisen verwendet werden?
Ja, unsere Matten sind tragbar und können auf Reisen leicht mitgenommen werden. Sie bieten eine einfache Möglichkeit, die Vorteile der Erdung überall zu erleben.
Kann ich die Matte für meine Haustiere verwenden?
Ja, sie sind auch für Haustiere geeignet. Durch direkten Kontakt mit der Matte können auch Tiere von den positiven Effekten der Erdung profitieren, einschließlich Stressreduktion und allgemeinem Wohlbefinden.
Wie wird es verwendet?
Schliessen Sie die Matte mit dem mitgelieferten Adapter an eine Steckdose. Dann berühren Sie die Matte direkt mit Hautkontakt, zum Beispiel durch darauf Sitzen, Stehen, auf dem Schreibtisch oder legen Sie es ans Fußende im Bett.